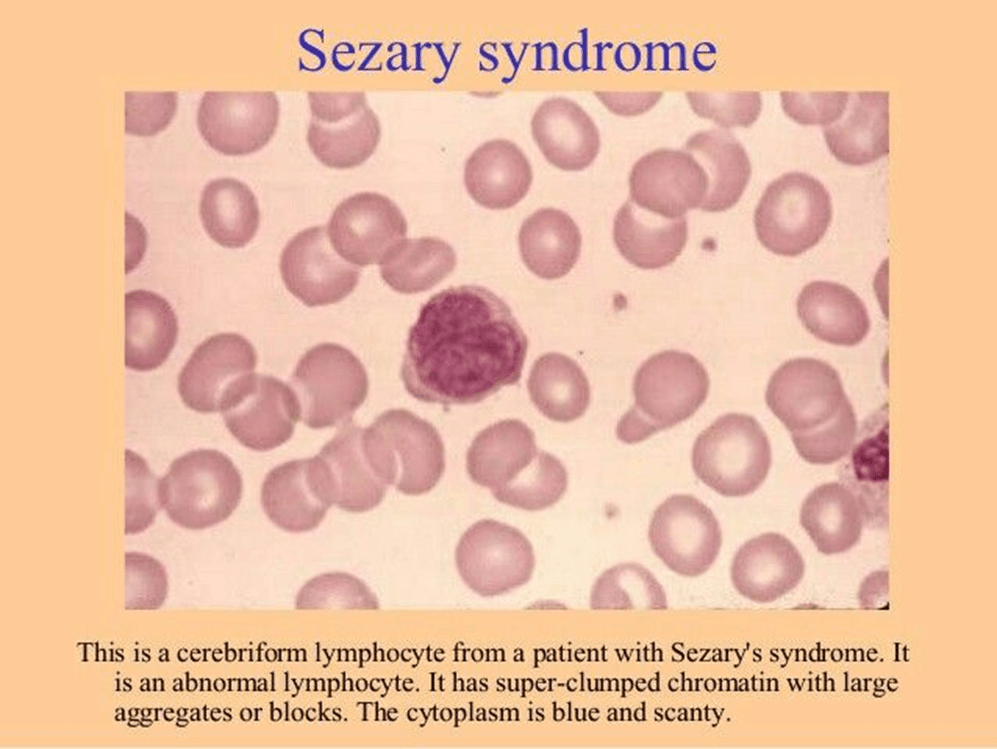

What Is Skin Cancer?

Malignant Melanoma Development


Breslow’s thickness


Staging System


Benign Tumours










NON-MELANOMA

Basal Cell Carcinoma
The table below presents key features and subtypes of basal cell carcinoma







Squamous Cell carcinoma
The table below presents key features of squamous cell carcinoma



Merkel Cell Carcinoma
The table below presents key features of Merkel cell carcinoma




Kaposi Sarcoma
The table below presents key features of Kaposi Sarcoma







Cutaneous T-cell Lymphoma

Soft Tissue Sarcoma






Sebaceous Carcinoma


Atypical Fibroxanthoma


Recommended Sources
Top Doctors: Dermatologist Dr. Bashir
Spotting Cancer: Skin Cancer Guide
Skin Cancer Research Journal Article by Dr. Emily Carter
References
Cambridge University Hospitals (2026) Skin cancer. Available at: https://www.cuh.nhs.uk/our-services/cancer-services/cancer-and-types-of-treatment/cancer-types-a-z/skin-cancer/ (Accessed: 5th February 2026)
Cancer Research UK (2026a) Types of non-melanoma skin cancer. Available at: https://www.cancerresearchuk.org/about-cancer/skin-cancer/types (Accessed: 5th February 2026)
Cancer Research UK (2026b) Kaposi’s sarcoma (Kaposi sarcoma cancer). Available at: https://www.cancerresearchuk.org/about-cancer/soft-tissue-sarcoma/types/which-treatments-are-used-for-kaposis-sarcoma (Accessed: 5th February 2026)
Cancer Research UK (2026c) Skin Lymphoma Cutaneous T cell lymphoma (CTCL). Available at: https://www.cancerresearchuk.org/about-cancer/non-hodgkin-lymphoma/types/skin (Accessed: 5th February 2026)
Cancer Research UK (2026d) Sebaceous gland carcinoma. Available at: https://www.cancerresearchuk.org/about-cancer/skin-cancer/types/sebaceous-gland-carcinoma (Accessed: 5th February 2026)
Cancer Research UK (2026e). What is melanoma skin cancer? Available at: https://www.cancerresearchuk.org/about-cancer/melanoma/about (Accessed: 5th February 2026)
Clark, W.H., From, L., Bernardino, E.A., and Mihm, M.C. (1969). The Histogenesis and Biologic Behavior of Primary Human Malignant Melanomas of the Skin. Cancer Research, 29(3), pp. 705-727.
Green, A.C. and Olsen, C.M. (2017). Cutaneous squamous cell carcinoma: an epidemiological review. British Journal of Dermatology, 177(2), pp.373–381. doi: https://doi.org/10.1111/bjd.15324.
Hextall, J. (2022). Skin cancer: how is it treated, and can it be cured? Available at: https://www.topdoctors.co.uk/medical-articles/skin-cancer-how-is-it-treated-and-can-it-be-cured/ (Accessed: 5th February 2026)
Kwa, R.E., Campana, K. and Moy, R.L. (1992). Biology of cutaneous squamous cell carcinoma. Journal of the American Academy of Dermatology, [online] 26(1), pp.1–26. doi: https://doi.org/10.1016/0190-9622(92)70001-V.
Liu, W., Dowling, J.P., Murray, W.K., McArthur, G.A., Thompson, J.F., Wolfe, R., and Kelly, J.W. (2006). Rate of growth in melanomas: characteristics and associations of rapidly growing melanomas. Archives of Dermatology, [online] 142(12), pp.1551–1558. doi: https://doi.org/10.1001/archderm.142.12.1551.
Oakley, A. (2012). Fitzpatrick skin phototype. Available at: https://dermnetnz.org/topics/skin-phototype (Accessed: 6th February 2026)
Oakley, A. (2024). Congenital melanocytic naevus.s Available at: https://dermnetnz.org/topics/congenital-melanocytic-naevi (Accessed: 7th February 2026)
Qasim, S. and Raghavan, S. (2023) Skin melanocytic tumor. Available at: https://www.pathologyoutlines.com/topic/skintumormelanocyticspitzoidmelanoma.html (Accessed: 7th February 2026)
Roky, A.H., Islam, M.M., Fuad, M., Mostaq, M.S., Mahmud, M.Z., Amin, M.N., and Mahmud, M.A. (2024). Overview of skin cancer types and prevalence rates across continents. Cancer Pathogenesis and Therapy, 3(2). doi: https://doi.org/10.1016/j.cpt.2024.08.002.
Sarcoma UK (n.d.) Angiosarcoma. Available at: https://sarcoma.org.uk/about-sarcoma/what-is-sarcoma/types-of-sarcoma/angiosarcoma/ (Accessed: 6th February 2026)
Scott, F.I., Mamtani, R., Brensinger, C.M., Haynes, K., Chiesa-Fuxench, Z.C., Zhang, J., Chen, L., Xie, F., Yun, H., Osterman, M.T., Beukelman, T., Margolis, D.J., Curtis, J.R., and Lewis, J.D. (2016). Risk of Nonmelanoma Skin Cancer Associated with the Use of Immunosuppressant and Biologic Agents in Patients with a History of Autoimmune Disease and Nonmelanoma Skin Cancer. JAMA Dermatology, 152(2), p.164. doi: https://doi.org/10.1001/jamadermatol.2015.3029.
Sung, H., Ferlay, J., Siegel, R.L., Laversanne, M., Soerjomataram, I., Jemal, A. and Bray, F. (2021). Global Cancer Statistics 2020: GLOBOCAN Estimates of Incidence and Mortality Worldwide for 36 Cancers in 185 Countries. CA: a Cancer Journal for Clinicians, [online] 71(3), pp.209–249. doi: https://doi.org/10.3322/caac.21660.
Swali, R., Limmer, A., and Tyring, S.K. (2020). Kaposi Sarcoma of the Medial Foot in an MSM, HIV-Negative Man: A Fifth Clinical Variant. Journal of Clinical and Aesthetic Dermatology, 13(10), pp.42–44.
Tidy, C. (2021). Basal cell carcinoma. Available at: https://patient.info/doctor/dermatology/basal-cell-carcinoma (Accessed: 6th February 2026)
Ting, S. (2025). Blue naevus. Available at: https://dermnetnz.org/topics/blue-naevus (Accessed: 7th February 2026)
Tommasino, M. (2019). HPV and skin carcinogenesis. Papillomavirus Research, [online] 7, pp.129–131. doi: https://doi.org/10.1016/j.pvr.2019.04.003.
Updated: February 2026. Next Review: May 2028














